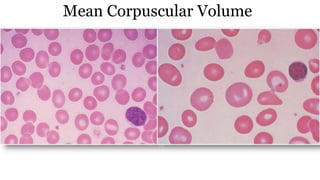
Mean Corpuscular Volume
MCV is average volume of the red blood cell
80-100 fl
>100 fl
<80 fl
The blood analyser >> microscopic observation
Microcytic + macrocytic cells =normal MCV
MCV = (hematocrit/red cell count) × 100
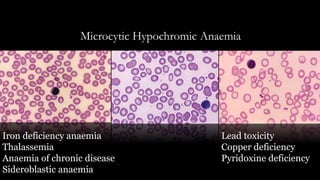
Microcytic Hypochromic Anaemia
Iron deficiency anaemia
Thalassemia
Anaemia of chronic disease
Sideroblastic anaemia
Lead toxicity
Copper deficiency
Pyridoxine deficiency
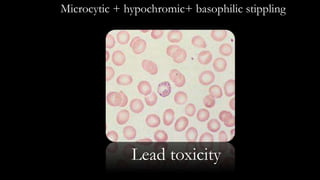
Microcytic + hypochromic+ basophilic stippling
Lead toxicity
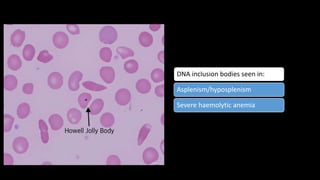
DNA inclusion bodies seen in:
Asplenism/hyposplenism
Severe haemolytic anemia
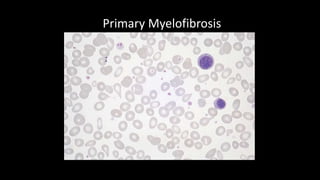
Primary Myelofibrosis
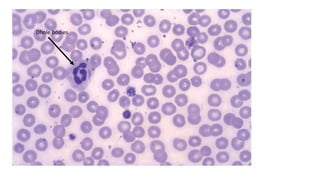
Selective marrow suppression of platelet production due
to—
– Drugs
– Infections
– Ethanol.
Ineffective thrombopoiesis due to—
– Folate or B12 deficiency.
Hereditary disorders
– May-Hegglin anomaly
– Wiskott-Aldrich syndrome
Dhole bodies
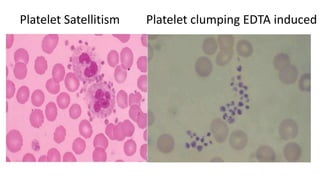
Platelet Satellitism Platelet clumping EDTA induced

The document provides an extensive overview of complete blood count parameters, including hematocrit, hemoglobin, white blood cells, and platelet counts, along with their normal ranges and various conditions leading to abnormalities. It discusses factors causing increased or decreased blood components, such as anemia, leukocytosis, and thrombocytopenia, as well as the clinical implications of these variations. Additionally, it details specific morphologies and their associations with different pathologies, emphasizing the significance of proper analysis in diagnosing hematological disorders.